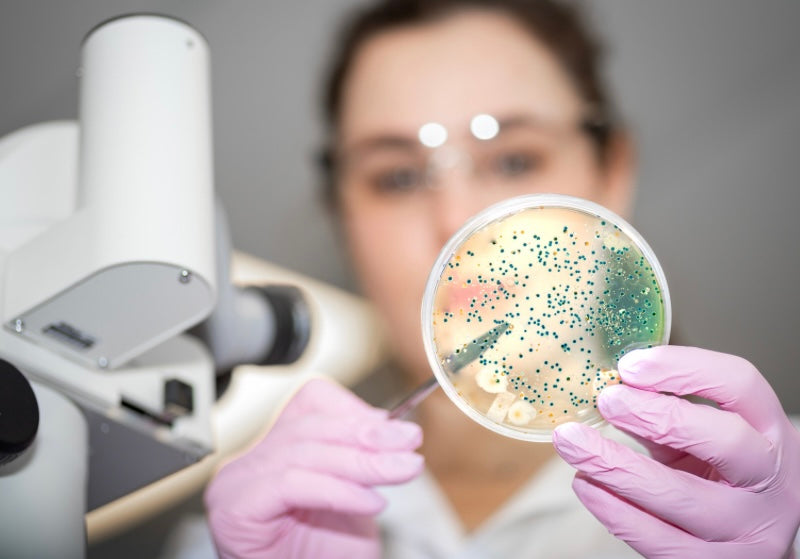

Understanding the Skin Microbiome: Why It’s Crucial for Healthy Skin
The skin is the body’s largest organ, serving as a physical barrier against environmental stressors such as pollutants, UV rays, and harmful bacteria. But the skin’s defense system doesn’t act alone—it is supported by the **skin microbiome**, a diverse ecosystem of microorganisms (bacteria, fungi, and viruses) that live on the skin’s surface. A healthy, balanced microbiome plays a critical role in maintaining healthy skin by supporting its barrier function, regulating the immune response, and protecting against pathogens.
This invisible community is essential for overall skin health, and any disruption to its balance can lead to skin issues like acne, eczema, dryness, and irritation. Plant-based skincare ingredients can nurture and protect this delicate ecosystem, helping to prevent these problems while promoting long-term skin health.
What Is the Skin Microbiome?
The skin microbiome refers to the trillions of microorganisms that naturally inhabit the surface of your skin. These microbes are not harmful; in fact, they are essential for skin function and health. Some key roles of the skin microbiome include:
1. Protecting Against Harmful Microbes:
The skin microbiome acts as a natural defense system by competing with harmful bacteria for space and resources. Beneficial microbes create an environment that discourages the growth of harmful pathogens, which could otherwise lead to infections or skin conditions like acne and dermatitis.
2. Strengthening the Skin’s Barrier Function:
A well-balanced microbiome helps maintain the skin’s barrier, which is vital for preventing moisture loss and keeping harmful substances out. This barrier function ensures that the skin remains hydrated and resilient against external irritants.
3. Regulating the Immune System:
The skin microbiome communicates with the immune system to help regulate inflammatory responses. When balanced, it helps prevent overactive inflammation that could lead to skin conditions like eczema, psoriasis, and rosacea.
4. Maintaining Skin pH:
The skin’s natural pH is slightly acidic (around 4.5-5.5), which is optimal for healthy microbial balance. A disrupted pH can lead to an imbalance in the microbiome, encouraging harmful bacteria to thrive.
Why a Balanced Skin Microbiome Is Crucial for Healthy Skin
A balanced microbiome is essential for overall skin health. When this balance is disrupted, it can trigger a variety of skin issues, including:
- Acne:
Imbalances in the skin microbiome can lead to an overgrowth of acne-causing bacteria such as *Cutibacterium acnes* (formerly *Propionibacterium acnes*), resulting in inflammation and clogged pores.
- Eczema and Dryness:
A weakened skin barrier can lead to water loss, causing dryness and making the skin more prone to irritation and eczema.
- Sensitivity and Redness:
An imbalanced microbiome can lead to overactive immune responses, causing skin to become more reactive to external triggers and resulting in redness, inflammation, and irritation.
- Infections:
Without a healthy population of beneficial bacteria, harmful pathogens can take over, leading to bacterial or fungal infections on the skin.
How Plant-Based Ingredients Support and Protect the Skin Microbiome
Plant-based ingredients are an excellent choice for supporting the skin microbiome because they work gently with the skin’s natural processes. Many synthetic ingredients, like harsh sulfates, alcohols, and preservatives, can strip away beneficial bacteria, leading to an imbalance in the microbiome. In contrast, natural, plant-derived ingredients help nurture and protect the delicate ecosystem of your skin. Here’s how they do it:
1. Prebiotic and Probiotic Ingredients:
Prebiotics and probiotics are key to maintaining a healthy microbiome. Prebiotics provide nourishment for the beneficial bacteria on your skin, while probiotics introduce live microorganisms that can help restore balance when the microbiome is disrupted.
- Prebiotics (such as inulin, derived from chicory root) help feed and support the growth of beneficial bacteria on the skin.
- Probiotics, often found in fermented plant extracts (like rice or soy), can restore and maintain healthy bacteria levels, reducing irritation and inflammation.
2. Soothing and Anti-Inflammatory Ingredients:
Many plant-based ingredients have anti-inflammatory properties, helping to calm the skin and prevent disruptions to the microbiome that can be caused by irritation or overactive immune responses.
- Chamomile and Calendula are known for their soothing properties, reducing redness and inflammation, which can help support a healthy microbiome by keeping the skin calm and balanced.
- Aloe Vera is rich in polysaccharides that hydrate the skin and reduce irritation, helping to maintain the skin’s natural defenses.
3. Antimicrobial Ingredients That Don’t Disrupt the Microbiome:
Some plant-based ingredients have natural antimicrobial properties, which help fight off harmful bacteria without disturbing the beneficial microbes on the skin.
- Tea Tree Oil has been used for centuries for its antibacterial and antifungal properties. Unlike harsh chemical alternatives, it can target harmful bacteria (such as those causing acne) without disrupting the overall balance of the skin microbiome.
- Neem Oil is another plant-based antimicrobial ingredient that can help protect against infections while supporting healthy skin balance.
4. Ingredients That Maintain Skin’s Natural pH:
A healthy skin pH is essential for maintaining a balanced microbiome. Many plant-based ingredients are naturally pH-balanced, making them ideal for supporting the skin’s microbiome.
- Rose Water has a natural pH that aligns with the skin’s acidic environment, helping to maintain a balanced microbiome.
- Jojoba Oil closely mimics the skin’s natural sebum, providing moisturization without disrupting the pH or clogging pores.
How to Support Your Skin Microbiome with Plant-Based Skincare
Incorporating plant-based ingredients into your skincare routine can help protect and nurture your microbiome. Here are some tips:
1. Avoid Harsh Cleansers:
Many cleansers contain ingredients like sulfates, which can strip the skin of its natural oils and beneficial bacteria. Opt for gentle, plant-based cleansers that cleanse without disrupting the microbiome.
2. Use Prebiotic and Probiotic Skincare:
Look for products that contain prebiotics and probiotics to support your skin’s microbial balance. These can help restore the microbiome after it’s been disrupted by environmental factors, stress, or other skincare products.
3. Hydrate with Natural Oils:
Plant-based oils like jojoba, rosehip, and argan oil nourish the skin without clogging pores or disrupting the microbiome. They help maintain the skin’s barrier, lock in moisture, and provide an environment where beneficial bacteria can thrive.
4. Soothing Ingredients for Sensitive Skin:
If you have sensitive or irritated skin, choose products with calming plant-based ingredients like chamomile, calendula, and aloe vera. These ingredients reduce inflammation, supporting a balanced and healthy microbiome.
The Power of Plant-Based Ingredients for a Healthy Skin Microbiome
The skin microbiome is a vital part of maintaining healthy, radiant skin. By nurturing this ecosystem with plant-based ingredients, you can protect your skin’s barrier, regulate inflammation, and prevent issues like breakouts, dryness, and irritation. Plant-based skincare products, with their gentle, natural formulas, offer the ideal solution for supporting a balanced microbiome while avoiding the harsh chemicals that can disrupt it. When your microbiome is healthy, your skin is better equipped to protect, heal, and maintain its natural beauty.